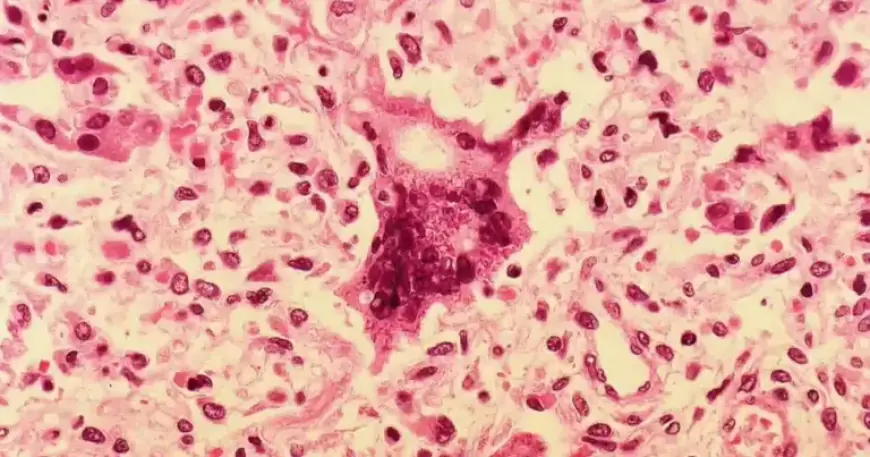
Southeast Michigan Measles Outbreak Reaches Seven Cases, Health Officials Confirm

Southeast Michigan Measles Outbreak Reaches Seven Cases, Health Officials Confirm
Health officials confirm the Southeast Michigan measles outbreak has grown to seven cases. The Washtenaw County Health Department says all patients were unvaccinated.
Cases and exposures
The first case was reported on March 11. Health officials say that adult likely contracted measles while in Florida.
The confirmed group now includes two adults, four children ages 5 to 17, and one child under age five. The most recent case involves a young child who may have been exposed at a hospital.
Washtenaw County has posted about a dozen exposure locations and dates on its website. Those sites span Washtenaw and Wayne counties.
The latest location added was the emergency room treatment area at Trinity Health Ann Arbor Hospital on McAuley Drive in Ypsilanti. The exposure window there was during the afternoon and evening hours of March 21.
Symptoms and prevention
Measles is highly contagious but preventable with vaccination. Symptoms can include high fever, cough, and a red rash.
- High fever
- Cough and runny nose
- Tiny white spots inside the mouth
- Red skin rash
Juan Luis Marquez, MD, MPH, medical director at Washtenaw County, said measles spreads quickly when people lack immunity. He urged anyone who might have been exposed to follow public health guidance to protect others.
Public health response
Washtenaw County is working with the Wayne County Health Department and the Michigan Department of Health and Human Services. Officials are investigating each case and doing community outreach.
Residents should check the health department site for exposure dates and locations. Filmogaz.com noted the report included video that originally aired on March 23, 2026.









































